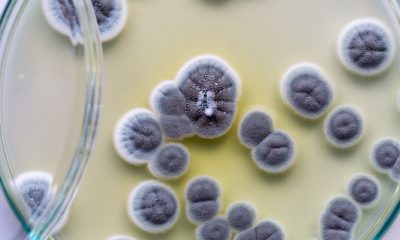

Em meio à pandemia do novo coronavírus, o Brasil, mais especificamente a Bahia, se viu diante de mais uma preocupação sanitária para lidar: a chegada do...



A Agência Nacional de Vigilância Sanitária (Anvisa) emitiu um alerta ontem (7) sobre uma investigação do primeiro caso positivo no país de Candida auris, fungo resistente...